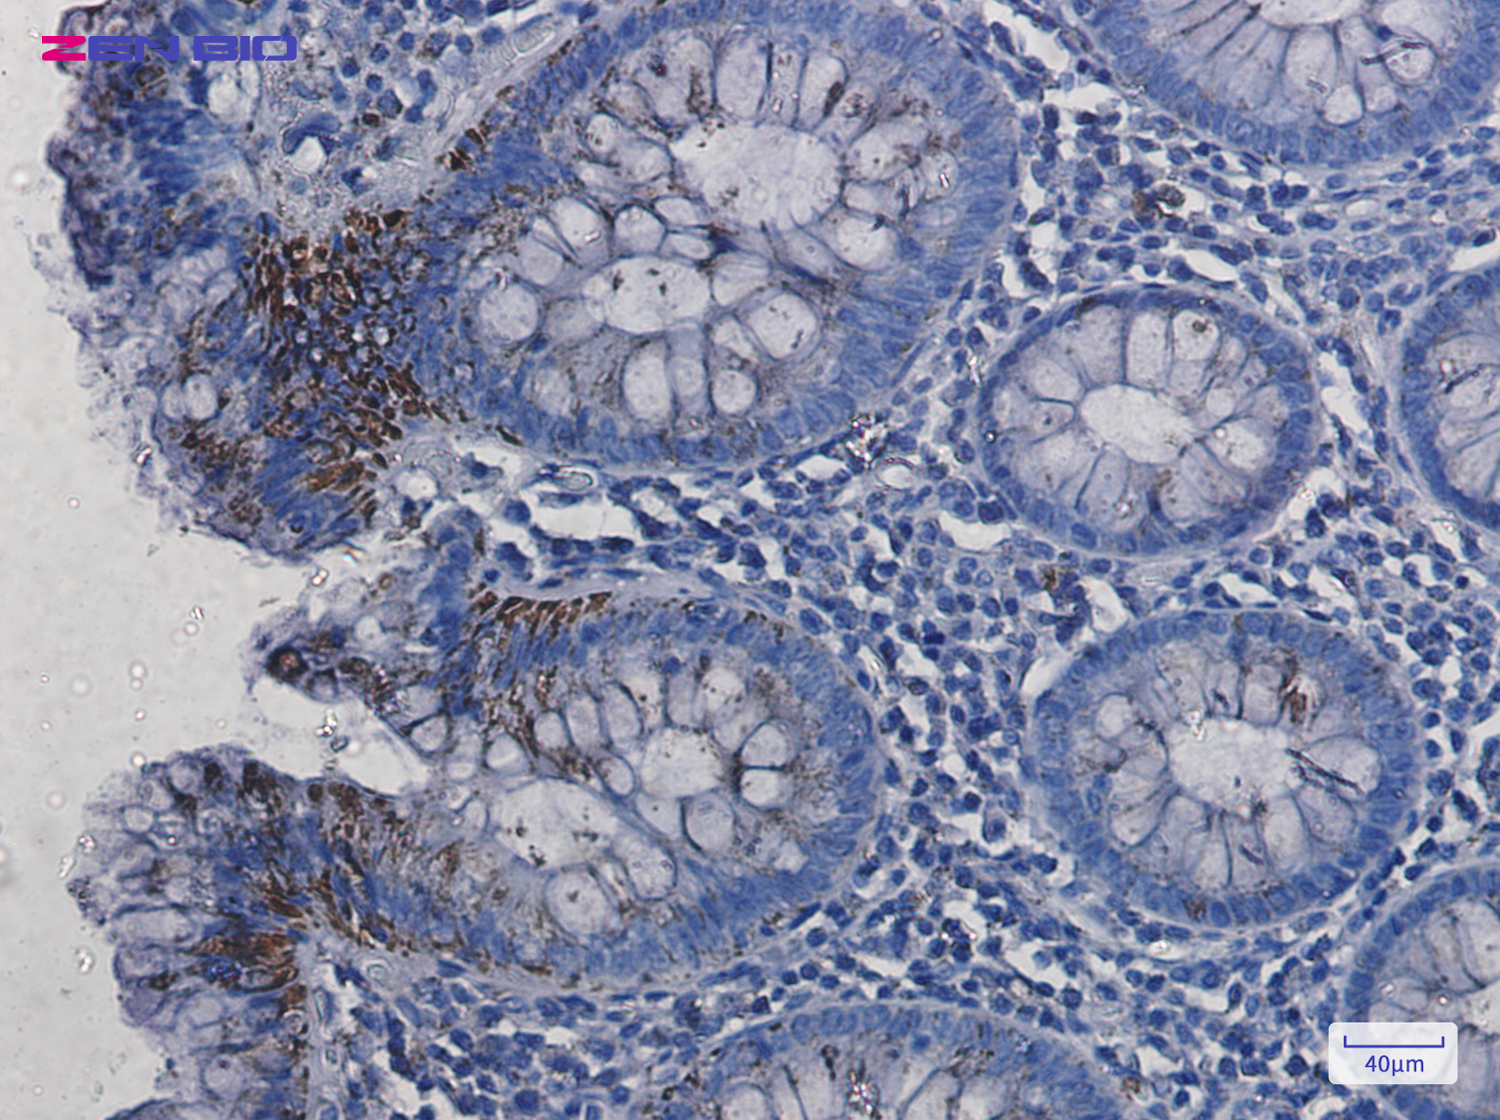
Immunohistochemistry of VDAC1 in paraffin-embedded Human colon cancer tissue using VDAC1 Rabbit pAb at dilution 1/50

-
Product Name
Anti-VDAC1 Rabbit antibody
- Documents
-
Description
VDAC1 Rabbit polyclonal antibody
-
Tested applications
WB, IHC-P
-
Species reactivity
Human, Mouse, Rat
-
Alternative names
PORIN; VDAC-1 antibody
-
Isotype
Rabbit IgG
-
Preparation
Antigen: A synthetic peptide of human VDAC1
-
Clonality
Polyclonal
-
Formulation
Supplied in 50nM Tris-Glycine(pH 7.4), 0.15M Nacl, 40%Glycerol, 0.01% sodium azide and 0.05% BSA.
-
Storage instructions
Store at -20°C. Stable for 12 months from date of receipt.
-
Applications
WB: 1/2000
IHC: 1/20-1/500
-
Validations

Western blot detection of VDAC1 in 293 cell lysates using VDAC1 Rabbit pAb(1:1000 diluted).Predicted band size:31KDa.Observed band size:31KDa.
Immunohistochemistry of VDAC1 in paraffin-embedded Human colon cancer tissue using VDAC1 Rabbit pAb at dilution 1/50

Western blot detection of VDAC1 in Jurkat,Rat Brain,C6 cell lysates using VDAC1 Rabbit pAb(1:1000 diluted).Predicted band size:31kDa.Observed band size:31kDa.
-
Background
Swiss-Prot Acc.P21796.Forms a channel through the mitochondrial outer membrane and also the plasma membrane. The channel at the outer mitochondrial membrane allows diffusion of small hydrophilic molecules; in the plasma membrane it is involved in cell volume regulation and apoptosis. It adopts an open conformation at low or zero membrane potential and a closed conformation at potentials above 30-40 mV. The open state has a weak anion selectivity whereas the closed state is cation-selective (PubMed:11845315, PubMed:18755977, PubMed:20230784, PubMed:8420959). May participate in the formation of the permeability transition pore complex (PTPC) responsible for the release of mitochondrial products that triggers apoptosis (PubMed:15033708, PubMed:25296756).
Related Products / Services
Please note: All products are "FOR RESEARCH USE ONLY AND ARE NOT INTENDED FOR DIAGNOSTIC OR THERAPEUTIC USE"
